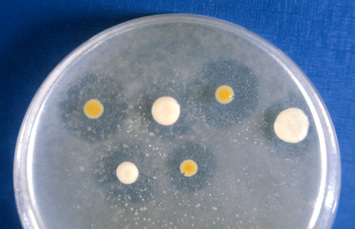

TRIBUTIRIN AGAR LIPOLÍTICOS MANTEQUILLA: Detección de microorganismos lipolíticos en mantequilla y otros productos lipídicos https://www.microkit.es/fichas/TRIBUTIRIN-LIPOLITIC-AGAR.pdf
COMPOSICIÓN
- Peptona untuosa 5,5 g
- Extracto de levadura 3,5 g
- Agar‑agar 15,0 g
- (Fórmula por litro)
- pH final: 7,5 ± 0,2
Tributirato de glicerilo (Tributirina) en frasco suplemento 100 ml
EL ASPECTO GRASO Y GRUMOSO DEL MEDIO ES NORMAL, a causa de la «Peptona untuosa».
PREPARACIÓN
Disolver 24 gramos del polvo en 1 litro de agua destilada que contenga 10 ml de tributirina (SDA078), llevando a ebullición y agitando vigorosamente hasta la completa suspensión.
Autoclavar a 121 ºC durante 10 minutos.
Agitar para eliminar grumos y verter en placas a unos 50 ºC sobre la muestra
PARA USO EXCLUSIVO EN LABORATORIO. MANTENGA EL BOTE BIEN CERRADO EN LUGAR SECO, FRESCO Y OSCURO.
DESHIDRATADO CODIGO: DMT125
CONTROL DE CALIDAD DEL MEDIO
Realizado en nuestro laboratorio; es prudente repetirlo en su laboratorio siempre que varíen las condiciones (más de 3 meses sin usar, tras desinfectar laboratorio, tras conservar a alta Tª, cuando adquiere aspectos extraños aunque no haya llegado la fecha de caducidad teórica de la etiqueta,…)
DESHIDRATADO: Untuoso, crema
PREPARADO: Estéril, Crema opalescente
CONTROL DE CRECIMIENTO 48-72 h a temperatura ambiente (21-28°C aproximadamente):
- Bacillus subtillis MKTA 6633, Bueno, No forma halo.
- Staphylococcus aureus MKTA 6538P, Bueno, dorado, en 48 horas forma halo.
- Staphylococcus epidermidis MKTA 12228, Bueno, en 48 horas no forma halo.
- Pseudomonas aeruginosa MKTA 9027, Excelente, pigmenta en 48 horas y forma halo.
- Yarrowia lypolitica MKTC 1468, Bueno, Forma halo.
PRESENTACIÓN: FRASCOS 100 ml, MEDIO DESHIDRATADO BASE (UNTUOSO) Y SUPLEMENTO.
NOTA: Medio de cultivo diseñado para detectar microorganismos lipolíticos (bacterias: Staphylococcus aureus, Pseudomonas aeruginosa…. y levaduras: Candida lypolitica, Yarrowia lypolytica….) en productos lácteos, cosméticos y otros productos. Se trata de una base nutritiva sencilla con el sustrato graso tributirato de glicerilo (tributirina). Este producto puede substituirse por mantequilla, pero los resultados en tal caso serán lentos y poco claros.
SIEMBRA
Inocular 1 ml de la muestra y su serie de diluciones decimales en placas preparadas o, mejor aún, en placas Petri sobre las que se añaden 20 ml del medio en frasco, fundido y enfriado a unos 45‑50 ºC. Incubar a 30 ºC aproximadamente, durante 2‑3 días
INTERPRETACIÓN
Contar las colonias que hayan producido un halo transparente de lipolisis a su alrededor. Los microorganismos que han atacado la tributirina también lo harán sobre la mantequilla.
TRIBUTIRIN AGAR LIPOLÍTICOS MANTEQUILLA
El usuario final es el único responsable de la eliminación de los microorganismos según la legislación medioambiental vigente. Autoclavar antes de desechar a la basura.
Si desea más información sobre nuestro TRIBUTIRIN AGAR (BASE) rellene nuestro formulario de contacto http://www.medioscultivo.com/contacto . O si lo prefiere póngase en contacto con nosotros a través de nuestro correo electrónico microkit@microkit.es o por teléfono en el nº 91-897 46 16